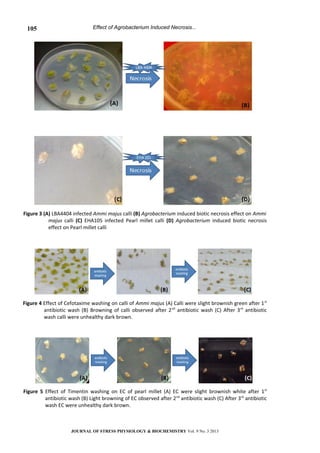
Effect of Agrobacterium Induced Necrosis...
Figure 3 (A) LBA4404 infected Ammi majus calli (B) Agrobacterium induced biotic necrosis effect on Ammi
majus calli (C) EHA105 infected Pearl millet calli (D) Agrobacterium induced biotic necrosis
effect on Pearl millet calli
Figure 4 Effect of Cefotaxime washing on calli of Ammi majus (A) Calli were slight brownish green after 1st
antibiotic wash (B) Browning of calli observed after 2nd
antibiotic wash (C) After 3rd
antibiotic
wash calli were unhealthy dark brown.
Figure 5 Effect of Timentin washing on EC of pearl millet (A) EC were slight brownish white after 1st
antibiotic wash (B) Light browning of EC observed after 2nd
antibiotic wash (C) After 3rd
antibiotic
wash EC were unhealthy dark brown.
JOURNAL OF STRESS PHYSIOLOGY & BIOCHEMISTRY Vol. 9 No. 3 2013
105

This document discusses the challenges of Agrobacterium-mediated genetic transformation in plants. Specifically, it examines the biotic and abiotic stress factors imposed on plant tissues during the transformation process, such as necrosis caused by Agrobacterium infection and phytotoxicity from antibiotic treatment. The study investigated these stress effects on the transformation of two plants - Ammi majus (a medicinal plant) and pearl millet (a cereal crop). It found the explant survival rates after transformation were low (8% for A. majus and 5% for pearl millet), and identified Agrobacterium infection, antibiotic treatment, and other factors as being responsible for lower transformation efficiency and survival. The document discusses strategies to